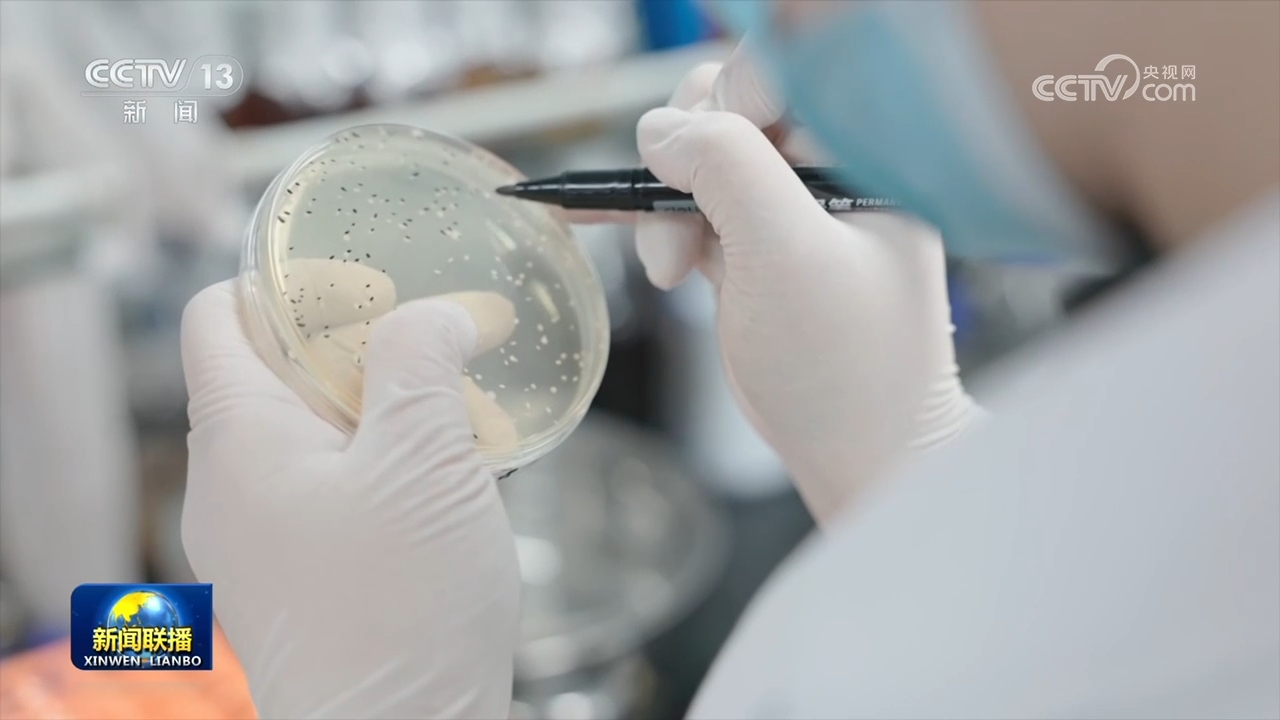

央视网消息(新闻联播):今年全国两会期间,习近平总书记在参加江苏代表团审议时强调,完成“十五五”经济社会发展目标任务,需要应对更加复杂的环境、解决更多深层次矛盾。江苏等经济大省处在改革开放前沿,要在研究新情况、解决新问题上下功夫、出经验。江苏深入学习贯彻习近平总书记重要讲话精神,因地制宜发展新质生产力,扎实推动高质量发展,确保“十五五”开好局、起好步。
今年全国两会上,习近平总书记在参加江苏代表团审议时,联系江苏实际就抓好“十五五”经济社会发展提出明确要求。总书记指出,发展新质生产力对于推动高质量发展、增强经济竞争力至关重要,江苏这方面基础较好,要努力走在前列。
牢记总书记嘱托,江苏组织召开了传达学习贯彻全国两会精神会议,把深入学习贯彻习近平总书记重要讲话精神,作为当前和今后一个时期全省上下的重大政治任务,始终沿着总书记指引的方向,准确把握自身在全国发展大局中的定位与责任,努力创造“十五五”发展更好实绩。

在加强原始创新和关键核心技术攻关、抢占科技制高点上实现新突破。
落实总书记要求,今年,江苏将加快共建上海(长三角)国际科技创新中心,推动苏州实验室、紫金山实验室建设,并以南京、苏州为支点,打造创新型城市,推进40项省科技重大专项、80项前沿技术研发和60项基础研究重点项目。
在促进创新链、产业链、资金链、人才链深度融合,推动科技成果高效转化应用上探索新途径。
眼下,江苏正深入推进高新区和高等院校“双高协同”,全省18个高新区和37家高校协同发展、双向赋能,进一步畅通产学研用转化通道。截至目前,试点高新区已梳理企业端技术需求1300多条,试点高校梳理并促成1000多项可转化科技成果与企业对接。
在优化提升传统产业、培育壮大新兴产业、超前布局未来产业上开创新局面。
就在这个月,全球规模最大的电子玻纤单体生产线在江苏成功点火,年产能达到3.9亿米,进一步提升我国高端电子基础材料自主供应能力。今年,江苏将推动新技术新产品新场景大规模应用,进一步做强新材料、集成电路、高端装备、低空经济等新兴产业,培育发展量子科技、生物制造、第六代移动通信等未来产业。
在进一步深化改革、破除制约新质生产力发展的体制机制障碍上取得新成果。
今年,江苏计划组建10家左右任务型创新联合体,深化教育科技人才一体改革,大力发展现代高科技服务业,新增1000名专业化技术经理人,培育30家技术标杆转移机构,推进人工智能“一人公司”创新发展。苏州是国家新一代人工智能创新发展试验区,今年,当地针对人机协同等智能经济新形态面临的资金技术支持不足、产业对接能力较弱等问题,先后出台培育发展行动计划、创业社区建设服务指南等政策,为创业者搭建起全周期服务平台。
迈上新征程,江苏牢牢把握高质量发展这个首要任务,持续在研究新情况、解决新问题上下功夫、出经验,以实干实绩奋力推进中国式现代化江苏新实践。




